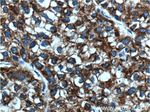
ACSL1 Antibody in Immunohistochemistry (Paraffin) (IHC (P))

Search
Proteintech
ACSL1 Polyclonal Antibody
{{$productOrderCtrl.translations['antibody.pdp.commerceCard.promotion.promotions']}}
{{$productOrderCtrl.translations['antibody.pdp.commerceCard.promotion.viewpromo']}}
{{$productOrderCtrl.translations['antibody.pdp.commerceCard.promotion.promocode']}}: {{promo.promoCode}} {{promo.promoTitle}} {{promo.promoDescription}}. {{$productOrderCtrl.translations['antibody.pdp.commerceCard.promotion.learnmore']}}
产品信息
13989-1-AP
种属反应
已发表种属
宿主/亚型
分类
类型
抗原
偶联物
形式
浓度
规格
纯化类型
保存液
内含物
保存条件
运输条件
产品详细信息
An anti-rat ACSL1 antibody recognized a band of the predicted 68 kDa in high-speed supernatant from rat liver and in human and murine SMCs, monocyte-derived macrophages, and murine peritoneal macrophages. It has 2 isoforms produced by alternative splicing.
Immunogen sequence: RLLMDDLKV LQPTVFPVVP RLLNRMFDRI FGQANTTLKR WLLDFASKRK EAELRSGIIR NNSLWDRLIF HKVQSSLGGR VRLMVTGAAP VSATVLTFLR AALGCQFYEG YGQTECTAGC CLTMPGDWTA GHVGAPMPCN LIKLVDVEEM NYMAAEGEGE VCVKGPNVFQ GYLKDPAKTA EALDKDGWLH TGDIGKWLPN GTLKIIDRKK HIFKLAQGEY IAPEKIENIY MRSEPVAQVF VHGESLQAFL IAIVVPDVET LCSWAQKRGF EGSFEELCRN KDVKKAILED MVRLGKDSGL KPFEQVKGIT LHPELFSIDN GLLTPTMKAK RPELRNYFRS QIDDLYSTIK V (349-698 aa encoded by BC050073)
靶标信息
The protein encoded by this gene is an isozyme of the long-chain fatty-acid-coenzyme A ligase family. Although differing in substrate specificity, subcellular localization, and tissue distribution, all isozymes of this family convert free long-chain fatty acids into fatty acyl-CoA esters, and thereby play a key role in lipid biosynthesis and fatty acid degradation.
仅用于科研。不用于诊断过程。未经明确授权不得转售。
生物信息学
蛋白别名: ACS1; ACSL1 isoform a; ACSL1 isoform c; Acyl CoA synthetase, long chain; Acyl-CoA synthetase 1; Arachidonate--CoA ligase; fatty acid Coenzyme A ligase, long chain 2; fatty-acid-Coenzyme A ligase, long-chain 1; fatty-acid-Coenzyme A ligase, long-chain 2; L LACS2; LACS 1; LACS 2; lignoceroyl-CoA synthase; Long-chain acyl-CoA synthetase 1; Long-chain acyl-CoA synthetase 2; Long-chain fatty acid-CoA ligase 2; long-chain fatty-acid-coenzyme A ligase 1; Long-chain-fatty-acid--CoA ligase 1; Long-chain-fatty-acid--CoA ligase, liver isozyme; OTTHUMP00000218457; OTTHUMP00000218460; OTTHUMP00000218462; OTTHUMP00000218465; Palmitoyl-CoA ligase 1; Palmitoyl-CoA ligase 2; paltimoyl-CoA ligase 1; Phytanate--CoA ligase; unnamed protein product
基因别名: Acas; Acas1; ACS; ACS1; ACSL1; Acsl2; COAA; FACL1; FACL2; FACS; LACS; LACS 1; LACS1; LACS2
UniProt ID: (Human) P33121, (Mouse) P41216, (Rat) P18163
Entrez Gene ID: (Human) 2180, (Mouse) 14081, (Rat) 25288